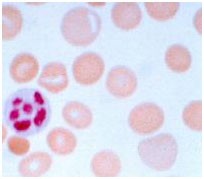

Case details
A 44-year-old man who had lost his job because of absenteeism presented to his physician complaining of loss of appetite, fatigue, muscle weakness, and emotional depression. The physical examination revealed a somewhat enlarged liver that was firm and nodular, and there was a hint of jaundice in the sclerae and a hint of alcohol in his breath. The initial laboratory profile included a hematological analysis that showed that he had anemia with enlarged red blood cells (macrocytic). A bone marrow aspirate confirmed the suspicion that he had megaloblastic anemia because it showed a greater-than-normal number of red and white blood cell precursors, most of which were larger than normal. Further analyses revealed that his serum folic acid level was 1.2 ng/mL (normal 2.5 to 20), his serum B12 level was 253 ng/mL (normal 200 to 900), but his serum iron level was normal.
What is the cause of megaloblastic anemia in this patient? What is its correlation with alcoholism?
Case discussion
The megaloblastic anemias are a group of disorders characterized by the presence of distinctive morphological appearances of the developing red cells in the bone marrow. The cause is usually a deficiency of either cobalamin (vitamin B12) or folate, but megaloblastic anemia may arise because of genetic or acquired abnormalities affecting the metabolism of these vitamins or because of defects in DNA synthesis not related to cobalamin or folate. Megaloblastic anemia in folate deficiency is identical to anemia resulting from vitamin B12 deficiency. However, the serum vitamin B12 level is normal in this patient, so that rules out vitamin B12 deficiency. Alcoholics, in particular, are at risk for folate deficiency because of impaired gastrointestinal absorption and poor nutrition. Folate is essential for many biochemical processes in the body, including DNA synthesis and red blood cell synthesis.
Megaloblastic anemia due to folate deficiency
Incidence
The prevalence of folic acid deficiency has decreased since the United States and Canada introduced a mandatory folic acid food fortification program in November 1998. People with excessive alcohol intake and malnutrition are still at high risk of folic acid deficiency.
Biochemical Basis of Megaloblastic Anemia
The common feature of all megaloblastic anemias is a defect in DNA synthesis that affects rapidly dividing cells in the bone marrow. All conditions that give rise to megaloblastic changes share in common a disparity in the rate of synthesis or availability of the four immediate precursors of DNA: the deoxyribonucleoside triphosphates (dNTPs): dA(adenine)TP and dG(guanine)TP (purines), dT(thymine)TP and dC(cytosine)TP (pyrimidines). In deficiencies of either folate or cobalamin, there is a failure to convert deoxyuridine monophosphate (dUMP) to deoxythymidine monophosphate (dTMP), the precursor of dTTP. This is because folate is needed as the coenzyme 5, 10-methylene-THF polyglutamate for the conversion of dUMP to dTMP; the availability of 5, 10-methylene-THF is reduced in either cobalamin or folate deficiency (Figure-1).
Cobalamin-Folate Relations
Folate is required for many reactions in mammalian tissues. Only two reactions in the body are known to require cobalamin. Methylmalonyl CoA isomerization, which requires Adenosylcobalamin and the methylation of homocysteine to methionine, requires both methylcobalamin and both 5-MTHF. In cobalamin deficiency, MTHF accumulates in plasma, while intracellular folate concentrations fall due to the failure of the formation of THF, the substrate on which folate polyglutamate is built. This has been termed THF starvation or the methylfolate trap (Figure 1). This theory explains the abnormalities of folate metabolism that occur in cobalamin deficiency and why cobalamin deficiency anemia will respond to folic acid in large doses.

Figure 1 shows the role of folic acid in DNA synthesis and methionine metabolism
Causes of folate deficiency
Folate deficiency can result from several possible causes, including inadequate ingestion, impaired absorption, and impaired metabolism, leading to an inability to utilize folate that is absorbed, increased requirement, increased excretion, and increased destruction.
- Inadequate ingestion of folate-containing foods: Poor nutrition is prevalent among people with alcoholism and patients with psychiatric morbidities, as well as elderly people (due to conditions such as ill-fitting dentures, physical disabilities, and social isolation). Because folates are destroyed by prolonged exposure to heat, people of certain cultures that involve traditionally cooking food in kettles of boiling water may be predisposed to folate deficiency. Moreover, for patients with renal and liver failure, anorexia and restriction of foods rich in protein, potassium, and phosphate contribute to decreased folate intake.
- Impaired absorption
- A decreased absorptive area due to small bowel resection or mesenteric vascular insufficiency would decrease folate absorption.
- Celiac disease and tropical sprue cause villous atrophy.
- The process of aging causes shorter and broader villi in 25% of the elderly population.
- Achlorhydria leads to the elevation of gastric pH above the optimal level (i.e., pH of 5) for folate absorption.
- Anticonvulsant drugs, such as Dilantin, interfere with mucosal conjugase, hence impairing folate absorption.
- Zinc deficiency also decreases folate absorption because zinc is required to activate mucosal conjugase.
- Bacterial overgrowth in blind loops, stricture formation, or jejunal diverticula likewise would decrease folate absorption.
- Impaired metabolism, leading to an inability to utilize absorbed folate: Antimetabolites that are structurally analogous to the folate molecule can competitively antagonize folate utilization. Methotrexate and trimethoprim are both folate antagonists that inhibit dihydrofolate reductase. Hypothyroidism has been known to decrease hepatic levels of dihydrofolate reductase as well as Methylene THFA reductase. Furthermore, congenital deficiency involving the enzymes of folate metabolism also can show impaired folate utilization. People with alcoholism can have very active alcohol dehydrogenase that binds up folate and thus interferes with folate utilization.
- Increased requirement: Factors that increase the metabolic rate can increase the folic requirement. Infancy (a period of rapid growth), pregnancy (rapid fetal growth), lactation (uptake of folate into breast milk), malignancy (increased cell turnover), concurrent infection (Immuno proliferative response), and chronic hemolytic anemia (increased hematopoiesis) all can result in an increased folate requirement.
- Increased excretion/loss: Increased excretion of folate can occur subsequent to vitamin B-12 deficiency. During the course of vitamin B-12 deficiency, methylene THFA is known to accumulate in the serum, which is known as the folate trap phenomenon. In turn, large amounts of folate filter through the glomerulus, and urine excretion occurs.
- Increased destruction: Superoxide, an active metabolite of ethanol metabolism, is known to inactivate folate by splitting the folate molecule in half between the C9 and N10 positions. The relationship between cigarette smoking and low folate levels has been noted as possibly due to folate inactivation in exposed tissue.
Clinical manifestations
- History-In folate deficiency, the patient’s history is important because it may reveal the underlying disorder. Very often, a patient presents with a history of excessive alcohol intake with concurrent poor diet intake. Other times, patients may be pregnant or lactating, may take certain drugs, such as phenytoin, sulfonamides, or methotrexate, may have chronic hemolytic anemia, or may have underlying malabsorption.
- Oral lesions –Some patients complain of a sore tongue or pain upon swallowing. The tongue may appear swollen, beefy, red, or shiny, usually around the edges and tips initially (Figure 2). Angular stomatitis may also be observed (Figure 3). These oral lesions typically occur at the time when folate depletion is severe enough to cause megaloblastic anemia, although occasionally, lesions may occur before the anemia.
- GI symptoms –Patients may present with GI symptoms, such as nausea, vomiting, abdominal pain, and diarrhea, especially after meals. Anorexia also is common and, in combination with the above symptoms, may lead to marked weight loss. However, an underlying malabsorption disorder could be causing these symptoms, as well as folate depletion. The lack of folate itself may not be the culprit.
- Hyperpigmentation- Patients with folate deficiency may have darkening of the skin and mucous membranes, particularly at the dorsal surfaces of the fingers, toes, and creases of palms and soles. Distribution typically is patchy. Fortunately, the hyperpigmentation gradually should resolve after weeks or months of folate treatment.
- A modest temperature elevation (<102°F) is common in patients who are deficient in folate, despite the absence of infection. Although the underlying mechanism is obscure, the temperature typically falls within 24-48 hours of vitamin treatment and returns to normal within a few days.
- Hematological manifestations– Folate deficiency can cause anemia. The presentation typically consists of macrocytosis and hypersegmented polymorph nuclear leucocytes (PMNs). The anemia usually progresses over several months, and the patient typically does not express symptoms as such until the hematocrit level reaches less than 20%. At that point, symptoms such as weakness, fatigue, difficulty concentrating, irritability, headache, palpitations, and shortness of breath can occur. Furthermore, heart failure can develop in light of high-output cardiac compensation for decreased tissue oxygenation. Angina pectoris may occur in predisposed individuals due to increased cardiac work demand. Tachycardia, postural hypotension, and lactic acidosis are other common findings. Less commonly, neutropenia and thrombocytopenia also will occur, although it usually will not be as severe as the anemia. In rare cases, the absolute neutrophil count can drop below 1000/mL, and the platelet counts below 50,000/mL.

Figure 2- Glossitis in folic acid deficiency

Figure 3- Angular stomatitis in folic acid deficiency
Laboratory Investigations
- Serum folate (reference range 2.5-20 ng/mL) and serum cobalamin (reference range 200-900 pg/mL)
- As the initial test, ruling out cobalamin deficiency is very important because folate treatment will not improve neurologic abnormalities due to cobalamin deficiency.
- Additional follow-up tests include serum homocysteine (reference range 5-16 mmol/L), which is elevated in B-12 and folate deficiency, and serum methylmalonic acid (reference range 70-270 mmol/L), which is elevated in B-12 deficiency only.
- Red blood cell folate levels (reference range >140 ng/mL) tend to reflect chronic folate status rather than acute changes in folate that are reflected in serum folate levels,
- Hematological Findings (Peripheral Blood film)
Oval macrocytes, usually with considerable anisocytosis and poikilocytosis, are the main features (Figure 4). The MCV is usually >100 fL unless a cause of microcytosis (e.g., iron deficiency or thalassemia trait) is present. Some of the neutrophils are hypersegmented (more than five nuclear lobes). There may be leucopenia due to a reduction in granulocytes and lymphocytes, but this is usually >1.5 x 109/L; the platelet count may be moderately reduced, rarely to <40 x 109/L. The severity of all these changes parallels the degree of anemia. In the nonanemic patient, the presence of a few macrocytes and hypersegmented neutrophils in the peripheral blood may be the only indication of the underlying disorder.
Figure – 4 – shows peripheral blood film in macrocytic anemia. Macrocytes are observed, and some of the red blood cells show ovalocytosis. A 6-lobed polymorph nuclear leucocyte is present.
- Bone Marrow
Bone marrow morphology is characteristically abnormal. Marked erythroid hyperplasia is present as a response to defective red blood cell production (ineffective erythropoiesis). Megaloblastic changes in the erythroid series include abnormally large cell size and asynchronous maturation of the nucleus and cytoplasm—ie, cytoplasmic maturation continues while impaired DNA synthesis causes retarded nuclear development.
- Ineffective Hematopoiesis-There is an accumulation of unconjugated bilirubin in the plasma due to the death of nucleated red cells in the marrow (ineffective erythropoiesis).
Mortality/Morbidity
Elevated serum homocysteine and atherosclerosis
Folate in the 5-methyl THFA form is a cosubstrate required by methionine synthase when it converts homocysteine to methionine. As a result, in the scenario of folate deficiency, homocysteine accumulates. Several recent clinical studies have indicated that mild-to-moderate hyperhomocysteinemia is highly associated with atherosclerotic vascular diseases such as coronary artery disease (CAD) and stroke. In this case, mild hyperhomocysteinemia is defined as the total plasma concentration of 15-25 mmol/L, and moderate hyperhomocysteinemia is defined as 26-50 mmol/L. Elevated homocysteine levels might act as an atherogenic factor by converting a stable plaque into an unstable, potentially occlusive lesion. Homocysteine is believed to have atherogenic and prothrombotic properties via multiple mechanisms.
Treatment
Fruits and vegetables constitute the primary dietary source of folic acid. The minimal daily requirement is about 50 mcg, but this may be increased several-fold during periods of enhanced metabolic demand, such as pregnancy.
Recommended Daily Allowance
- Males: 400 mcg/d
- Females: 400 mcg/d
- Pregnant: 600 mcg/d
- Nursing: 500 mcg/d
Deficiency treatment
0.4-1 mg per day. Large doses of 5–15 mg folic acid daily are given in patients with severe absorption. It is essential to exclude cobalamin deficiency before large doses of folic acid are given, and deficiency if present must be corrected, otherwise, cobalamin neuropathy may develop, despite a response of the anemia of cobalamin deficiency to folate therapy.
Prevention
Patients whose folic acid deficiency is related to dietary factors should be counseled to include green vegetables and fruit in their diet. Prophylactic treatment of pregnant patients and patients with chronic hemolytic anemias can prevent folic acid deficiency due to the increased requirement for folate in these conditions.
Supplements and food fortification
Folic acid is added to a variety of foods, the most important of which are flour, salt, breakfast cereals and beverages, soft drinks, and baby foods. Folic acid is available as oral preparations, alone or in combination with other vitamins or minerals (e.g,. iron), and as an aqueous solution for injection. As folic acid is only poorly soluble in water, folate salts are used to prepare liquid dosage forms. Folinic acid (also known as leucovorin or citrovorum factor) is a derivative of folic acid administered by intramuscular injection to circumvent the action of dihydrofolate reductase inhibitors, such as methotrexate. It is not otherwise indicated for the prevention or treatment of folic acid deficiency.




